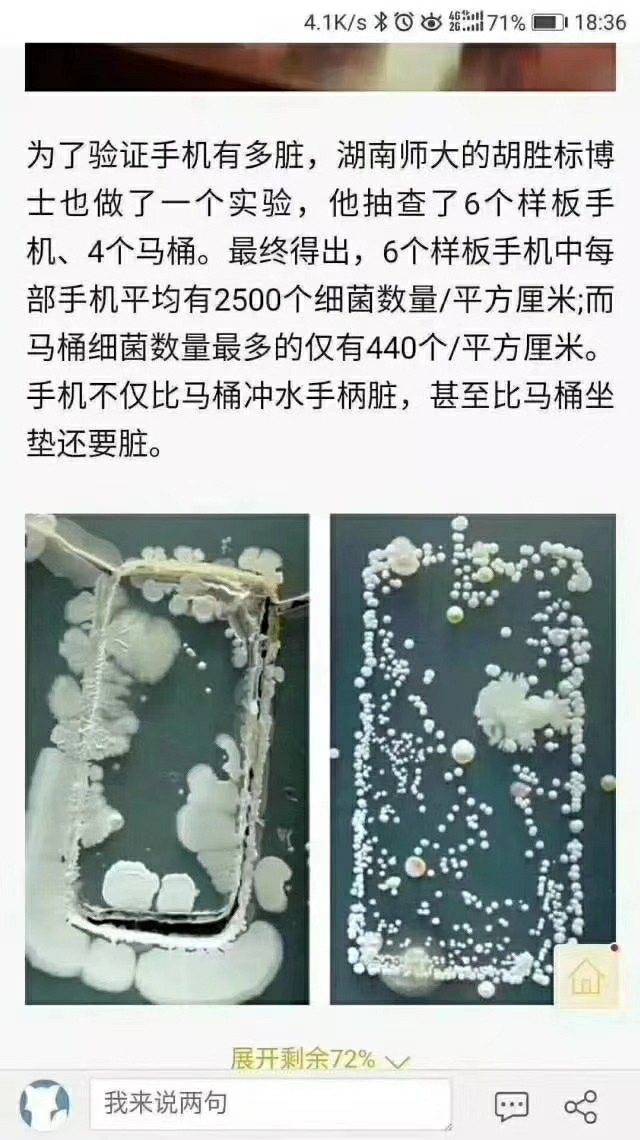
膜结手机纳米防护是不是骗局,膜结手机纳米防护效果怎么样

膜结手机纳米防护是什么?
膜结手机纳米防护是一个公益性的创业项目,也是天津强宁纳米科技有限公司的一个有知识产权的产品,因为天津强宁纳米科技有限公司,是一家从事纳米技术推广与研发为一体的综合性高科技企业治理与纳米系列产品的开发与应
用,其膜结隶属公司旗下的纳米防护技术,业务遍布于全国各大城市!


膜结手机纳米防护由天津强宁纳米科技针对手机研发的专利产品,采用纳米蓝光阻断技术有效色散蓝光减少手机蓝光对眼睛的伤害!手机原屏就是载体,将一种新型的纳米材料纳米防护液作用于手机屏幕表面可以和手机屏幕里二氧化硅上的羟基发生反应,形成硅氧键,从而形成一层均匀的纳米保护层,不仅可以保护手机屏幕还可以保护眼睛,双重防护!

品牌“膜结”寓意结束帖膜,用全新的眼睛看世界,让客户每天使用一个干净透亮,绿色健康的产品!为什么要结束手机贴膜呢?
随着时代的不断发展进步,手机成为人们不可缺少的通讯工具,手机的功能越来越多,我们使用的频率越来越长,中国人有一个习惯, 一个新手机买来大家都喜欢贴上一张膜来使用,目的是为了保护手机屏幕(防划或防摔),随着手机的功能越来越多,我们使用的频率越来越长,眼健康问题引起了大家的重视,手机贴膜的确能保护手机屏幕不会被划伤,但手机贴膜透光率差,容易偏色,看时间长了容易导致使用者眼干、眼涩、头晕眼花、视力模糊等症状!


再就是贴膜容易起皮翘脚,容易滋生细菌,据权威部门报道手机贴膜超过3个月不更换,膜下面的细菌含量是厕所马桶细菌含量的十八倍之多。
看到贴膜有这么多缺点,那我不贴膜,裸屏使用不就可以了吗?非也,为什么呢?因为新买来的手机上有一层防指纹涂层,这就是我们新手机买来为什么感觉到屏幕黑亮黑亮的,但随着我们的使用,防指纹涂层很快就会被磨损掉,防指纹涂层一但被磨损掉以后,手机屏幕的手感比较涩、容易脏、不易清洁、透光率差、还容易滋生细菌,那么贴膜伤眼睛,不贴膜缺点又这么多,这个时候就要提到我们膜结纳米防护了,膜结纳米防护是以手机原屏为载体用一种新型纳米材料,作用在手机屏幕表面,手机屏幕肉眼着是平的而在显微镜下面着是凹凸不平的,纳米比细菌还小,是头发丝的五百分之一,也是迄今最小的衡量单位,肉眼看不到,来填充它的空间,形成纳米结构来提升屏幕的耐磨擦程度,提升它的透光率,提升它的油污易清洁能力和护眼程度,在保护手机屏幕的同时还可以保护眼睛,双重防护,并且还可以重复做防护,永远让你使用一个干净透亮绿色健康的手机,用全新的眼睛看世界,享受品质生活。


膜结手机纳米防护六大功能功效:1.提升屏幕的耐摩擦,2.色散蓝光 缓解眼疲劳保护眼,3.手感顺滑 触控灵,4.疏水易清洁 油污轻轻一抹干净如新,5.增亮高清 阳光下看手机依然清晰,6.弧度曲屏都能完美贴合!

随着5G时代的来临,折叠屏柔性屏的上市,贴膜只是夕阳产业,而膜结手机纳米防护才是行业发展的新趋势,并且膜结手机纳米防护整个行业的引领者,膜结手机纳米防护只是公司旗下的一个板块,经过产品的不断研发目前涉及的领域非常广泛,包括电子产品,金属饰品,手表,眼镜,汽车,石材,木材,纺织品等等一系列的纳米防护产品!

膜结”手机纳米防护它是一个新生事物,冷门,是非传统的一个公益性创业项目,因项目还没有成型。大部分客户对这个公益性创业项目没有认知,一般客户都会把这个项目当成一个给手机贴膜的地摊生意,单纯在销售产品,这个认知是错误的。“膜结”手机纳米防护它是一个公益性创业项目,我们做这个项目的目的就是要改变人们手机贴膜使用方式,习惯以及思维观念。我们为什么要改变人们手机贴膜使用方式?因为在无数事实科学依据面前证明手机贴膜伤眼睛,我们做膜结纳米防护的目的就是让客户每天使用一个干净透亮绿色健康的产品,用全新的眼睛看世界,享受品质生活!我们做的是品牌,产品只是项目的一部分,我们是依托产品做项目,而不是在单纯销售产品!

膜结手机纳米防护:优势一。专利产品,优势二。通过质量管理体系认证的公司,优势三,央视展播品牌,优势四,四板挂牌企业,优势五,唯一一家有品牌形象代言的.优势六。规模最大,全国各省市区办事处近4。百家,可就近实地考察,有保障。
亮点一,自主研发,自主产权,有专业的研发团队及合作实验室!亮点二,引进德国纳米技术,并聘请德国技术专家成为本公司技术顾问,为公司新产品的开发做出了优异的贡献。亮点三,膜结爱眼传播中心正式成立,每一位膜结人都是传递眼健康的使者。亮点四,别人叫镀膜,我们叫防护。亮点五,别人都是镀膜液,我们是防护包,亮点六,不一样的产品理念,亮点七,不一样的培训制度,亮点八,不一样的经营模式。

膜结手机纳米防护是迎合时代发展,顺应国策,近视已经成为国病,中国的近视率比例全世界第一,眼健康问题已经被国家重视,为了提高人们对眼健康的意识,膜结”爱眼文化传播中心在2019年半年度产品学术交流会期间正式成立,每一个“膜结”人都是“膜结”爱眼文化传播中心的志愿者!


膜结手机纳米防护是带有公益性的创业项目,膜结手机纳米防护以公益促项目,以项目养公益,走的就是公益之路,眼健康之路,品牌之路,长久发展之路
“膜结”人的初心就是用我们的产品改变人们手机贴膜使用的方式,(贴膜伤眼睛)让人们每天用一个干净透亮,绿色健康的产品,一部健康的手机!


“膜结”人的使命:直到用我们的产品改变中国几亿人手机贴膜使用的方式习惯及思维观念为止,最终打造中国纳米防护行业品牌,膜结纳米防护专家,让社会上一大批三无人员(无学历,无技术,无关系)都能到“膜结”这个平台实现自己的创业梦,实现时间自由,财富自由,收入轻轻松松超过白领!


关爱眼健康从膜结开始…
爱护自己的眼睛从撕掉钢化膜开始…